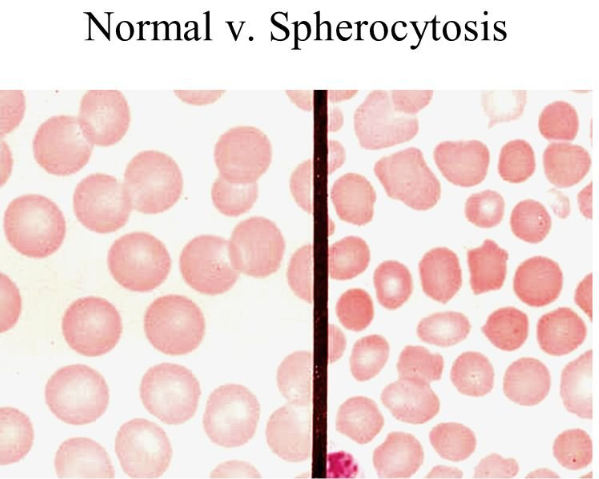

Hereditary Spherocytosis (HS)는
적혈구 세포골격 단백질 이상으로 인해
동그란 구형의(spherical) 적혈구가 만들어지고,
이로 인해 비장을 통과하지 못하고 비장에서 파괴(용혈)되면서
빈혈, 황달 등을 유발하는 가장 흔한 유전성 용혈성 빈혈입니다.
HS는 상염색체 우성(Autosomal Dominant, AD)으로 유전하기 때문에,
가족력이 흔합니다.
유전성 구형 적혈구증은,
α-spectrin, β-spectrin, Ankyrin, Band 3 protein 이라고 하는 세포막의 구성 성분의 이상으로,

① 세포골격의 불안정성 증가
② Na⁺ 유출 증가로 인한 세포 내 수분 증가
③ 수분 저류로 인한 적혈구가 원반형에서 구형(spherocyte)으로 변화
④ 비장에서 쉽게 인식되어 용혈되어 빈혈과 황달
이러한 과정에 의해서일어나게됩니다.

증상은 용혈성 빈혈, 즉 용혈 hemolysis 피가 깨지면서 생기는 빈혈로,
만성적이고 재생성 빈혈 (깨지고 다시 재생되고를 반복하는 형태의 빈혈로 망상적혈구 숫자가 증가됨) 입니다.
빌리루빈이라는 것은 적혈구가 파괴될때 생성되는 노란색 색소인데,
혈중에 빌리루빈 수치가 높아지게되면, 황달이 발생합니다.
신생아기부터 바로 용혈이 발생하면서, 빌리루빈이 많이 체내에 증가하게되고(unconjugated hyperbilirubinemia)
이는, 빌리루빈 수치 증가로 인해 황달이 잘생깁니다.

10세 이후까지 치료되지 못하고 있는 경우, 비장이 커지는 현상이 발생합니다.
용혈이 일어나는 비장의 기능 과다고 인해 비장이 비대, 비장종대(splenomegaly)가 발생합니다.

또한 빈혈로 인해 성장이 저하되는 성장지연,
만성적인 미세혈관 장애로 인핸 만성적인 궤양(chronic leg ulcer),
그리고 갖장 심각한 합병증은,
Parvovirus B19 감염 시, 이 바이러스는 적혈구 생성세포만 선택적으로 억제하게되는데,
안그래도 용혈이 되면서 적혈구가 깨지는데,
적혈구 전구세포 억제로 인해 골수무형성 위기(aplastic crisis)가 발생하면
급격한 빈혈이 발생하여 생명이 위험할수 있습니다.
진단 검사 소견으론,
피검사상에서 빈혈, 망상적혈구 증가, 고빌리루빈혈증 (unconjugated)이 발생하고,
혈액 도말검사에서
Spherocyte (구상적혈구)가 발견됩니다.
이는, 작고 중앙 창백부가 없는 형태로 (central pallor 소실) 관찰됩니다.
그외 구형 적혈구는 정상적인 적혈구 보다 취약하고 쉽게 파괴된다는 현상을 이용해서 감별합니다.
삼투압 취약성 검사 (Osmotic fragility test) 에서는,
삼투압 현상을 이용하여, 저장액 내속에 적혈구를 담구었을떄,
정상 적혈구보다 구상적혈구가 더 쉽게 파괴된다는 점으로 감별하는 것입니다.

자가용혈 검사 (Autohemolysis test) 는
포도당이없는 환경에 적혈구를 두었을때, 적혈구가 얼마나 파괴되는 지를 보는검사로,
HS는 15~45% 용혈되지만,
정상은 5% 이내로 용혈됨을 이용해서 감별합니다.
Coombs test라는 것은 면역학적 원인에 의해서 용혈이 되는 경우 양성으로 나오는 검사인데,
HS에서는 음성이 되는데, 이는 용혈의 기전이 면역성 용혈성 빈혈이 아닌 기계적 용혈이기 때문입니다.
그외 가족력이 있다는 점과, 비장비대 소견을 보면 의심할 수 있습니다.
이상으로,
유전구형적혈구증 (Hereditary Spherocytosis, HS) - 유전구상적혈구증 원인 유전 증상 진단 입니다.
'소아 혈액질환' 카테고리의 다른 글
| 백혈구(WBC)의 양적 이상 : 호중구 증가증 호중구감소증 림프구 증가 호산구증가 (0) | 2025.08.05 |
|---|---|
| 유전구형적혈구증 Hereditary Spherocytosis (HS) 치료 – 비정절제술 수혈, 엽산 보충, 철분보충 (2) | 2025.08.04 |
| 철결핍성 빈혈 iron deficiency anemia : 진단 지표와 철분 치료 용량 피검사 (5) | 2025.07.28 |
| 소아청소년 철결핍성 빈혈 (IDA, iron deficiency anemia) 원인 나이 철섭취부족, 모유수유 우유, 출혈 조산 미숙아 (0) | 2025.07.25 |
댓글